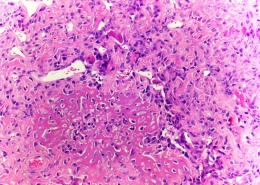

Jahresbericht & Revisionsbericht 2025
Erhalten Sie spannende Einblicke in unserer Tätigkeiten im Jahr 2025: welche Projekte wurden umgesetzt und wie konnten wir die betroffenen Familien entlasten?
Förderprojekte 2026
Sie möchten erfahren, welche Förderprojekte wir aktuell unterstützen? Verschaffen Sie sich eine Übersicht mit einem Klick auf das PDF.
Finanzielle Sofort- und Direkthilfe
Dank rascher und unbürokratischer Übernahme von krankheitsbedingten Mehrkosten entlasten wir die Familien.
Rechtssprechstunde am UKBB
Die Rechtssprechstunde schliesst eine Versorgungslücke und hilft entscheidende Weichen in sozialversicherungsrechtlichen Bereichen frühzeitig zu stellen.
Coop-Wertgutschein Elternküche
Elternküche am UKBB: Verpflegung für Familien krebskranker Kinder während des Spitalaufenthalts – schnell, unkompliziert und stärkend.
Psycho-Onkologische Betreuung
Betroffene und deren Angehörigen erhalten eine zielgerichtete Unterstützung bei der Bewältigung der veränderten Lebenssituation. Dazu zählt eine lückenlose und niederschwellige psychologische Begleitung auf der Kinderkrebsstation.
Pädiatrische Palliative Care am UKBB
Individuelle Begleitung in der besonderen Lebensphase – rund um die Uhr erreichbar, mit medizinischer und psychosozialer Hilfe.
Kit und das Leuchten der Punkte
„Kit und das Leuchten der Punkte“ ist ein Kinderbuch über Kinderkrebs, Freundschaft und Dazugehören für Familien, Schulen und Kliniken.
Ratgeber für Eltern von krebskranken Kindern
Der Ratgeber unterstützt Familien bei Kinderkrebs mit verständlichen Informationen zu Sozialversicherungen, Rechten und Hilfsangeboten.
Auf- und Ausbau neuer Bereich Public Affairs & Lobbying
Kinderkrebs Schweiz baut aktuell den neuen Bereich Public Affairs & Lobbying auf. Ziel ist es, die Anliegen von krebskranken Kindern, Survivors und ihren Familien gezielt in politische Prozesse einzubringen und zu sensibilisieren.
Nanas Lunchbox
Nanas Lunchbox schenkt Familien Entlastung und gemeinsame Zeit – mit frisch gekochten Mahlzeiten und liebevollen Details.
SunCare – Hautscreening nach Kinderkrebs
SunCare – Durch konsequenten Sonnenschutz und regelmässige Hautscreenings lässt sich das Risiko von Hautkrebs deutlich senken.
Beauty-Workshops – Trotz Krebstherapie wohl fühlen
Tipps & Tricks zum Thema Beauty – für unsere jungen Patienten:innen ein echter Gewinn.
Früherkennung von Lungenschäden
Besser atmen nach dem Krebs – Früherkennung rettet Lebensqualität. Forschungsprojekt zeigt wann erste Anzeichen der Lungenschäden entstehen.
Mehr Unterstützung bei chronischen Schmerzen
Wiederkehrende Schmerzen bei krebskranken Kindern können chronisch werden und ihre Lebensqualität sowie Psyche stark belasten.
Behandlung rezidivierter Sarkomen bei Kindern
Neue Zelltherapie bei betroffenen Kindern mit rezidivierten Sarkomen – eine vielversprechende neue Möglichkeit der Immuntherapie.
Herzenswünsche erfüllen
In all der Schwere soll etwas Leichtigkeit liegen und die Herzenswünsche der Kinder erfüllt werden.
ZaZa – Zahngesundheit für Kinder mit Krebserkrankung
ZaZa im UKBB: Bessere Zahnpflege für krebskranke Kinder – mit Fachwissen, Hilfsmitteln und Aufklärung für eine optimierte Mundhygiene.
WeCanDays 2025
WeCanDays stärken Kinderkrebs-Survivors mit Austausch, Workshops & Nachsorge-Inputs – ein Wochenende zum Auftanken & Vernetzen.
Elterngruppe Basel – Auszeit für Familien
Auszeit für Familien – Wochenende in Stoos. Zeit mit anderen, die in der gleichen Situation sind, zu verbringen, hilft vielen Familien zu spüren, dass sie nicht allein sind.
Informationsplattform „Kinderkrebs Schweiz“
Informationen zu Kinderkrebs: Infos zu Therapie, Alltag, Spätfolgen und Nachsorge. Für Betroffene, Angehörige und Survivors.
Elternwochenende „Time-out“
Vom Loslassen und Vertrauen – eine fachlich begleitete Auszeit für Eltern von Survivors.
SPOG – Kinderonkologie Forschung Basel
Wir fördern die Kinderonkologie-Forschung für die Regio Basiliensis mit 150’000 Franken. Ziel: bessere Therapien, mehr Lebensqualität für krebskranke Kinder.
Herzensbilder
Herzensbilder schenkt Familien emotionale Fotos als bleibende Erinnerung – wir unterstützen dieses wertvolle Projekt in Basel.
Entspannungsangebot für Familien
Entspannung und Selbstfürsorge für Familien krebskranker Kinder – direkt im UKBB. Kraft tanken, loslassen, heilen: ein wertvolles Unterstützungsangebot.
Freizeitangebote Eintrittsgutscheine
Freizeitangebote für betroffene Familien – dem Spitalalltag für einen Moment entfliehen um den familiären Zusammenhalt zu stärken.
Johannes Barth neu im Stiftungsrat
Seit Dezember 2025 verstärkt Johannes T. Barth den Stiftungsrat der Stiftung für krebskranke Kinder, Regio Basiliensis.
Kinderkrebsforschung: Frist bis 31. März 2026
Wir finanzieren qualitativ hochstehende Kinderkrebsforschungsprojekte lokal, effizient und zukunftsweisend.
Unterstützung von EHC Basel & Grand Casino Basel
Das Grand Casino Basel stellte für jedes an einem Heimspiel erzielte Tor des EHC Basel einen festen Spendenbetrag von 50 Franken zur Verfügung. Insgesamt kamen so 2’150 Franken zusammen.
Pink Flower Day bei Camlog
Camlog sammelt beim Pink Flower Day 4’000 CHF für krebskranke Kinder. Die Spende unterstützt das Projekt ZaZa zur Zahngesundheit bei Kindern mit Krebs.
Tennis Charity Night
Charity Night in der Bar Rouge am 23.10.25: Party, Tombola & Auktion zugunsten krebskranker Kinder. Jetzt Ticket sichern & Gutes tun!
Family Days bei Emil Frey, Basel-Dreispitz
Treffen Sie uns am 18. & 19. Oktober 2025. Ihre Kinder können Kraft-Karten gestalten, Sie lernen unsere Arbeit kennen. Sogar Speis und Trank gibt es vor Ort.
Nachruf
Wir nehmen Abschied von Prof. em. Dr. med. Michael J. Mihatsch – langjähriger Weggefährte und unermüdlicher Unterstützer unserer Stiftung.
Spendenscheck aus Charity-Water-Projekt
EuroAirport und Dufry spenden 347’000 € aus dem Charity-Water-Projekt für krebskranke Kinder und ihre Familien in und um Basel.
Spendenmailing
Dieses Jahr sammeln wir zweckgebunden für den Förderbereich „Projekte für mehr Lebensqualität“.
Danke Basel Tattoo 2025
Beim Basel Tattoo 2025 wurden 7’500 CHF für krebskranke Kinder gespendet – durch Depotspenden. Ein grosses Merci!
Basler Kantonalbank: Spende zum Kinderkrebsmonat
Im Kinderkrebsmonat sammelten die Basler Kantonalbank und die Community 25’000 Franken für krebskranke Kinder. Ein Herz für Basel.
Danke Kiwanis Club Basel Spalen
Herzlicher Empfang: Kiwanis Club Basel Spalen überreicht 15’000 Franken aus dem run4kids – Dank für Einsatz, Spenden & Gespräche.
Bachem AG spendet 3’000 Franken
Im Rahmen eines internen Gesundheitstags mit dem Schwerpunkt „Krebsprävention“ hat die Bachem AG eine besondere Aktion initiiert – mit grossem Herz für Familien in einer Ausnahmesituation.
Comedy Dinner am 3. Oktober 2025
Lachen trifft Genuss – Das Comedy Dinner mit Marco Rima und Dani von Wattenwyl. Jetzt Tickets sichern und dabei sein.
Julia Lehmann zur Geschäftsführerin der Stiftung gewählt
Der Stiftungsrat freut sich darauf, gemeinsam mit Julia Lehmann die Stiftung im Sinne der betroffenen Kinder, Jugendlichen und Familien weiterzuentwickeln.
Cinemagics am 25. September 2025
Cinemagics ist ein neues, faszinierendes Eventformat, das die Grenzen zwischen Bühne und Leinwand verschwimmen lässt.
Früherkennung von Spätfolgen
Swiss Childhood Cancer Survivor Study: So fördern wir die Erforschung von Spätfolgen, um Survivors gezielt zu helfen.
Elternwohnung
Die Familienwohnung mit Parkplatz liegt direkt beim UKBB. So kann die Familie jederzeit beieinander sein. Die Nutzung ist für die betroffenen Familien kostenlos.
Tagebuchset-Stammzelltransplantation
Das Tagebuchprojekt begleitet Kinder bei Stammzelltransplantation – zur Verarbeitung, Stärkung und als Ausdrucksform im langen Klinikalltag.
Infektionen nach Stammzelltransplantation vorbeugen
Studie zu Letermovir bei Kindern nach Stammzelltransplantation: Ziel ist eine sichere Dosierung zur Vorbeugung von Infektionen.
Nicht-invasive Echtzeit-Atem-Analyse für zielgerichtete Therapie
Studienziel ist, die Diagnose durch Atem-Analysen zu beschleunigen, um eine zeitnahe, zielgerichtete Therapie zu ermöglichen.
Nebennieren Insuffizienz bei Leukämie: der vermeidbare Mangel an Stresshormonen
Studie zu Cortison bei Leukämie: Ziel ist es, Hormonmangel früh zu erkennen und Kinder vor vermeidbaren Nebenwirkungen zu schützen.
Familien und Jugend-Rehabilitation
Die Familienorientierte Rehabilitation hilft der gesamten Familie bei der Reintegration, dient der psychischen und physischen Stabilisierung aller Mitglieder und verstärkt den medizinischen Therapieerfolg des erkrankten Kindes.
Schnelltest kindlicher Knochen- und Weichteiltumoren
Neue Methode mit deren Hilfe eine zuverlässige Diagnose bereits in wenigen Stunden möglich sein könnte und Wartezeit erspart bleibt.
Warum unsere Stiftung unterstützen?
Wir nennen Ihnen fünf gute Gründe für Ihr Engagement.
Spendenaktion #zeigeHerz
Wie viele Leuchtherzen für die erkrankten Kinder und deren Familien tatsächlich unterwegs waren, erfahren Sie hier.
Eventmagie: Jedes verkaufte Ticket unterstützt uns
Für jedes verkaufte Ticket zu den kommenden Terminen werden 5.- Franken an unsere Stiftung gespendet.
Koch- und Geschichtenbuch
Warum heissen Speisen wie sie heissen. Warum gibt es hier Bismarckheringe oder dort Kaiserschmarrn. Das ideale Geschenk zu Weihnachten.
Kinderkrebsmonat September
Machen Sie mit bei der Aktion #MiniMightyCancerFighters und unterstützen damit krebskranke Kinder und ihre Familien.
Dufry Basel & EuroAirport Basel
Erfolgreiche „Charity Water“ Spendenaktion für krebskranke Kinder in der Regio Basiliensis.
Jahresbericht 2023
Erhalten Sie spannende Einblicke in unserer Tätigkeiten im Jahr 2023: welche Projekte wurden umgesetzt und wie konnten wir die betroffenen Familien entlasten?
Neurofilament als Biomarker für Hirn- und Nervenschädigung
Damit könnte eine frühzeitige Erkennung, Nachverfolgung und Optimierung der Therapie erzielt werden.
Zusammen gehen und verstehen
Das Projekt „Zusammen gehen und verstehen – Ein Angebot, damit Kinder psychisch gesund bleiben, wenn Familienmitglieder körperlich schwer erkranken“ verfolgt vor allem ein präventives Ziel.
Optimierte Diagnostik kindlicher Hirntumoren
Dies ermöglicht künftig eine individualisierte Anpassungen der Operationsstrategie sowie den Beginn tumorspezifischer Zusatztherapien bereits bei der Operation.
Kinderspitalradio JoJo
Die Idee: den Spitalaufenthalt angenehmer und abwechslungsreicher zu machen.
just ASK us – Körperbild, Sexualität und Fruchtbarkeit
Beratungsangebot zu Themen rund um Körperbild, Sexualität und Fruchtbarkeit bei krebsbetroffenen Jugendlichen und jungen Erwachsenen.
Europa-Park Besuch der Elterngruppe Basel
Eine Gelegenheit unbeschwert zu geniessen und den Krebs für einen Moment zu vergessen.
Bioinformatiker „Kindliche Leukämien“
Die Arbeit eines guten Bioinformatikers ist heute essentiell für den Erfolg in der Pädiatrischen Grundlagenforschung.
Kunst für den guten Zweck
Erwerben Sie eines der begehrten Kunstobjekte von Martin Oeggerli und unterstützen Sie damit krebskranke Kinder in Basel.
Eishockey-Fans aufgepasst
Am 2. Februar findet das letzte Spiel der Qualifikation der ersten Mannschaft des EHC Basel statt. An diesem Abend veranstaltet der EHC das „Fasnachts Game für krebskranke Kinder“.
Wechsel in der Geschäftsführung
Das neue Jahr bringt einen Wechsel in der Geschäftsführung mit sich. Prof. Volker Dittmann übergibt sein Amt an Prof. Markus Tolnay.
Swiss Childhood Cancer Survivor Study (SCCSS)
Die SCCSS ist eine national und international einzigartige Kohorten-Studie, welche mögliche Spätfolgen nach einer Krebserkrankung im Kindesalter und deren Risikofaktoren systematisch erforscht.
Gemeinsam helfen
Grossherzige Spendenaktion des Inner Wheel Club Basel-Riehen. 13’000 Franken für die psycho-onkologische Betreuung.
Kinderkrebsmonat September
Helfen Sie uns Bewusstsein und Solidarität für an Krebs erkrankte Kinder zu schaffen.
Checkübergabe der Baloise
Herzlichen Dank an das Team der Baloise für diese wertvolle Unterstützung. Eine kreative Idee mit echtem Impact!
Gesuchseingabe Stipendien – Einreichung bis 1.3.2024
Mit Stipendien unterstützen wir Weiterbildungen für Forschende Ärztinnen und Ärzte sowie Pflegende.
Benefizkonzert 19. Juni 2023
Der Eintritt ist frei, es wird um eine Kollekte gebeten. Türöffnung 17:15 Uhr, Beginn Konzert 18:00 Uhr.
Jahresbericht 2022
Wir sagen Danke. Danke an Sie und an all die Menschen und Institutionen, die uns helfen zu helfen.
App-Entwicklung „Therapie- und Planungstool“
Die App, die helfen wird, den Familienalltag nach der Diagnose Kinderkrebs zu organisieren.
Immuntherapie
Nicht alle Krebsformen sprechen gleichermassen darauf an, die genauen Gründe dafür sind nicht vollständig geklärt.
Kindliche Leukämien – Stipendium Studentenstelle
Dank des Stipendiums kann an den Studien, welche auf die molekularen Mechanismen einer hochaggressiven Form der akuten myeloischen Leukämie fokussieren, angeknüpft werden.
CardioOnco Studie
Förderung der «CardioOnco-Studie» zur frühzeitigen Erkennung von Herzproblemen nach einer Krebserkrankung im Kindesalter.
Besseres Verständnis für kindliche Knochentumoren
Ziel ist, die Zuverlässigkeit in der richtigen Einordnung und das Verständnis für die Ursachen der Erkrankungen zu verbessern.
Webseite „Herznachsorge für Survivors“
Informationen rund um das Herz – von Risiken bis spezialisierte, interdisziplinäre kardioonkologische Beratung.
Porsche und Michael Lang zu Besuch im UKBB
Eine kurze Auszeit vom Spitalalltag – das ermöglichte das Porsche Zentrum Basel gemeinsam mit Michael Lang vom FC Basel.
Lebensqualität – während und nach der Behandlung
Ergänzende Angebote, die den Behandlungsmarathon begleiten, lassen Kinder und ihre Lieben Kraft und Hoffnung schöpfen.
Bye bye alter Einzahlungsschein
Das Ende des roten und orangenen Einzahlungsscheines naht. Wir erklären Ihnen, wie Sie uns unkompliziert ab dem 1. Oktober 2022 weiterhin mit einer Spende unterstützen können.
Aufruf: Onlinebefragung zur Krebsregistrierung
Gesucht: Patient*innen für eine Umfrage zur Krebsregistrierung. Bitte an Personen weiterleiten, welche nach dem 1.1.2020 an Krebs oder einer Vorstufe erkrankt sind.
Verbesserung von Tumorbehandlungen
Dank neuer Technik Verbesserung und Individualisierung bei Tumorbehandlung von seltenen Tumoren bei Kindern.
Schwangerschaft nach Stammzelltransplantation
Schwangerschaften sind nach einer Stammzelltransplantation möglich. Die Wahrscheinlichkeit sinkt jedoch mit der Ganzkörperbestrahlung.
SPOG Forschungsprogramm 2021
Wir unterstützen 2021 die Forschung der Schweizerischen Pädiatrischen Onkologie Gruppe SPOG mit 100’000 Franken. Die SPOG koordiniert und verantwortet ein umfassendes klinisches Forschungsprogramm für Kinder und Jugendliche in der Schweiz.
Die aufgefädelte Krankengeschichte
Die bunten Glasperlen helfen bei der Verarbeitung der Therapie, dienen als Belohnung, Motivation und spenden Mut.
Veränderungen im Stiftungsrat
Der Frühling bringt personelle Änderungen im Stiftungsrat mit sich: Wegen der in unseren Statuten festgelegten Alters- und Amtszeitbegrenzung wurde das Präsidium neu besetzt und ein ganz neues Mitglied in den Stiftungsrat gewählt.
Internationaler Kinderkrebstag
Gerade wenn es um Kinder geht, können sich viele immer noch nicht vorstellen, dass die schwere Erkrankung auch vor den Kleinsten nicht Halt macht. Um so wichtiger ist es, dass wir darüber sprechen!
Basler Stadtlauf 2021
2021 war unsere Aktion „Zeige Herz für krebskranke Kinder“ am Basler Stadtlauf wieder ein grosser Erfolg.
Was ist eigentlich Psycho-Onkologie
Krebstherapien haben Nebenwirkungen, immer wieder flammen Zweifel auf, ob alles gutgehen wird. Diese und andere Probleme muss jedes kranke Kind und dessen Familie persönlich meistern. Aber nicht alleine.
Kulturelle Vielfalt im Gesundheitswesen
Krebskranken Kindern und ihren Familien mit Migrationshintergrund eine Stimme geben, um ihre Perspektive besser zu verstehen und ihre Gesundheitsversorgung zu verbessern.
Epitheloides Sarkom – ein bösartiger Weichteiltumor
Bislang ist nur wenig über die molekularen Mechanismen bei der Entstehung dieses Tumors bekannt. Mit diesem Projekt sollen die molekularen Veränderungen weiter entschlüsselt werden.
Basler Liedertafel – Benefizkonzert
Konzerte der Extraklasse – das waren die beiden Benfizkonzerte die die Basler Liedertafel zu Gunsten unserer Stiftung veranstaltet hat.
Videoportraits „Menschen hinter unserer Stiftung“
Erfahren Sie mehr über die Menschen hinter unserer Stiftung. Unsere Videoportraits Serie wird regelmässig erweitert.
Visana spendet 10’000 Franken
Seit Jahren unterstützt Visana wohltätige Institutionen, damit diese notleidenden Menschen noch besser helfen können. Anlässlich ihres 25-jährigen Jubiläums unterstützt Visana schweizweit ausgewählte Projekte und Einrichtungen – auch unsere Stiftung.
Videoportraits „Menschen hinter unserer Stiftung“
Sie möchten uns besser kennenlernen? Dann sehen Sie sich unsere Videos „Menschen hinter unserer Stiftung“ an.
Jahresbericht 2020
Wir blicken wir auf ein Jahr voller Solidarität und Hilfsbereitschaft zurück. Erfahren Sie, wie wir die uns anvertrauten Mittel eingesetzt haben und was wir für krebsbetroffene Kinder und ihre Familien im letzten Jahr bewegen konnten.
Internationaler Kinderkrebstag
7121 Kraniche schmücken als Zeichen der Solidarität den Eingang zum Universitäts-Kinderspitals beider Basel (UKBB).
Kranich-Ketten für eine Spende
Die fröhlich-bunten Kranich-Ketten konnten gegen eine Spende erworben werden. Bereits am Nachmittag des 16. Februars waren alle Ketten vergriffen. Alle Einnahmen fliessen vollumfänglich in die Forschungsförderung.
Herzensbilder – Spendenaktion der BKB
Was für eine tolle Nachricht – die Basler Kantonalbank spendet uns 8000 Franken über ihrer Aktion #vonbaselfürbasel.
Bestellung Origami-Blätter
Vielen Dank, dass Sie unsere Aktion unterstützen möchten. Nutzen Sie unser Bestellformular und wir senden Ihnen die gewünschte Anzahl Origami-Blätter.
Faltanleitung
Versuchen Sie es: falten Sie gemeinsam mit Familie, Freunden oder mit Ihrem Team so viele Kraniche wie möglich. Faltanleitungen erhalten Sie als PDF oder Video.
Die Geschichte hinter unserer Aktion
Der Kranich ist in Japan ein heiliger Vogel, der seit hunderten von Jahren lebt. Und wenn eine kranke Person 1000 Papierkraniche faltet, wird sie wieder gesund werden. Lesen Sie hier mehr über die Legende.
1000 Kraniche für einen Wunsch
Einer japanischen Legende nach geht für denjenigen, der 1000 Kraniche faltet, ein Wunsch in Erfüllung. Unser grösster Wunsch ist, dass zukünftig alle krebskranken Kinder und Jugendliche eine Chance auf ein langes Leben ohne Spätfolgen ihrer Krebstherapie haben. Unterstützen Sie uns dabei.
Kinderkrebsforschung
Wir finanzieren qualitativ hochstehende Forschungsprojekte lokal, effizient und zukunftsweisend. Erfahren Sie mehr.
Absage Basler Stadtlauf
Leider wurde der Basler Stadtlauf, wie so viele Veranstaltungen in diesem Jahr, abgesagt. Das ist schade, aber verständlich. Davon lassen wir uns die Stimmung aber nicht verderben und verraten Ihnen schon heute, dass es eine wunderschöne Aktion geben wird, mit der Sie uns ebenfalls unterstützen können.
Zolli-Abo für betroffene Familien
Die Krebserkrankung eines Kindes stellt das Familienleben auf den Kopf. Von vielen wissen wir, wie wichtig es ist, immer mal wieder den Spitalalltag hinter sich zu lassen und ein klein wenig Normalität zu erleben. Daraus ist die Idee des Zolli-Abos entstanden, welches alle Familien bei Neudiagnose erhalten.
Neuigkeiten über Social Media erfahren
Wer uns auf Social Media folgen möchte, wird auf Facebook und Instagram fündig: stiftungkinderkrebs eingeben, Profil öffnen und uns liken.
Wenn das Unfassbare eintritt
Pro pallium hilft Familien, deren Kinder verstorben sind, auf mehreren Stufen und mit verschiedenen Angeboten. Wir unterstützen das Angebot der Trauerbegleitung finanziell, weil wir von der Wichtigkeit überzeugt sind.
Jahresbericht 2019
Im Jahr 2019 konnten wir über 630’000 Franken für Projekte zugunsten betroffener Familien einsetzen. Lesen Sie in unserem Jahresbericht, was wir bereits bewegen konnten und in Zukunft bewegen möchten.
Geschichte der Stiftung
Seit über 30 Jahren helfen wir krebskranken Kindern in der Region. Jetzt gibt es die ganze Geschichte zum Lesen.
ZEWO-Rezertifizierung
Mit einem hervorragenden Prüfergebnis von 99 prozentiger Erfüllung der 21-ZEWO-Standards dürfen wir das Gütesiegel für die nächsten fünf Jahre erneut tragen.
Absage Benefizgala
Aufgrund der aktuellen Situation, haben wir uns dazu entschieden, unsere Benefizgala, die für den 12. September 2020 unter dem Motto «Tango Seasons» geplant war, abzusagen. Geplant ist nun eine Durchführung im Jahr 2021.
Covid-19 und Kinderkrebs
Informationen zu Covid-19 unsere Dachorganisation Kinderkrebs Schweiz.
Lesegenuss
Wer etwas mehr über das Haus erfahren möchte, in dem wir unser Office haben, wird sich über diese erstaunliche Geschichte des „kleinen Wohnhauses“ im Garten des Wildt’schen Hauses freuen.
Kinoabend «Buster Keaton» am 11. Februar
Anlässlich des Internationalen Kinderkrebstages am 15. Februar 2020 laden wir bereits am 11. Februar zu einem Kinotag im Stadtkino Basel ein.
Kinderkrebskonferenz am 15. Februar 2020
Anlässlich des Internationalen Kinderkrebstages am 15. Februar 2020 lädt Kinderkrebs Schweiz gemeinsam mit seinen Mitgliedsorganisationen zur 2. nationalen Kinderkrebskonferenz in Bern ein.
Charity Flohmarkt – Danke
Das Swissôtel Le Plaza hat für unsere Stiftung einen Charity Flohmarkt veranstaltet. Wir sagen Danke für 2’523.63 Franken die aus den Verkäufen an unsere Stiftung gespendet wurden.
Basler Benefiz Guggenkonzert
Am 2. Dezember findet das Basler Benefiz Guggenkonzert statt. Der Spendenerlös kommt dieses Jahr unserer Stiftung zugute – eine wahnsinnige Ehre für uns.
Let’s Kanga mit Nadine
Let’s Kanga – Nadine bietet am 12. Dezember eine KANGA-Schnupperstunde zu Gunsten unserer Stiftung an. An diesem Tag können Mamis mit ihrem Baby schnuppern kommen und so viel für diese Trainingseinheit bezahlen wie sie möchten. Der Erlös geht an unsere Stiftung.
Benefizveranstaltung von Kiwanis Birstal
Am Mittwoch, 27. November lädt Kiwanis Birstal zur Benefizveranstaltung zu Gunsten krebskranker Kinder im Theater Fauteuil ein. Um 19.00 Uhr gibt es einen Apéro riche im Kaisersaal und im Anschluss um 20.00 Uhr die Vorstellung HD-Soldat Läppli im Fauteuil.
Benefiz-Vortrag: Der Tod in der Oper
Die Oper wird vielfach als die unrealistischste Kunstform von allen angesehen. Prof. Dr. med. Volker Dittmann, Geschäftsführer unserer Stiftung, wird am 26. November aus einer spannenden Perspektive aufzeigen, dass sehr viel Wirklichkeit in der Oper gezeigt wird.
Sportlich-sozial unterwegs
Was für eine tolles Engagment von Losinger Marazzi. Das Team ist am 14. Basler Bruggelauf mit Herz für uns gestartet.
„Ja“ zu 14 Wochen Betreuungsurlaub für Eltern schwerkranker Kinder
In einer historischen Entscheidung hat sich der Nationalrat am 23. September nun für einen Betreuungsurlaub von 14 Wochen für Eltern von schwerkranken Kindern ausgesprochen.
Veranstaltungshinweis: Survivors
Am 9. November findet im Kantonsspital Aarau AG eine Informationsveranstaltung für Survivors einer Krebserkrankung im Kindes- oder Jugendalter, betroffene Familien und interessierte Fachpersonen statt.
Tolle Unterstützung Dank Kuchenverkauf
Im Rahmen einer Sammelaktion hat uns die Klasse 2c der Fachmaturitätsschule Basel eine Spende von 1’238 Franken zukommen lassen.
PanCare Meeting in Basel
Die nächsten drei Tage widmen wir uns ganz der Nachsorge ehemaliger Kinderkrebspatienten und -patientinnen. Das diesjährige PanCare-Herbstmeeting findet hier bei uns in Basel statt.
Kinderkrebs: geheilt, aber nicht ganz gesund
Als Mitgliedsorganisation des Dachverbands Kinderkrebs Schweiz tragen wir die Sensibilisierungskampagne „Kinderkrebs: geheilt, aber nicht ganz gesund“ mit. Dank medizinischer Fortschritte, überleben heute vier von fünf Kindern und Jugendlichen ihre Krebserkrankung. Unsere Stiftung unterstützt die Kinder und deren Familien während der kräfteraubenden Therapie. Mit der Heilung ist aber nicht alles überstanden, teilweise massive Spätfolgen beeinflussen das […]
Symposium Kinderonkologie
Auf Einladung unserer Stiftung für krebskranke Kinder und der onkologischen Abteilung des Universitäts-Kinderspitals beider Basel besuchten zahlreiche Gäste aus vielen Institutionen, mit denen wir kooperiert, am 24. Mai 2019 im UKBB ein Fachsymposium zu aktuellen Fragen der Kinderonkologie. In seiner Begrüssungsansprache gab Prof. Dr. Volker Dittmann einen kurzen Überblick zur 30-jährigen Geschichte der Stiftung. Am […]
Gleichberechtigte Behandlungsmöglichkeiten
Medikamente für krebskranke Kinder werden nicht immer automatisch von den Krankenkassen übernommen. Manche Eltern müssen darum kämpfen, dass die Behandlungskosten für ihr Kind bezahlt werden. Zur Angst um das Kind, kommt die Sorge, alleine für die Heilungskosten aufkommen zu müssen. Gleichberechtigte Behandlungsmöglichkeiten für alle Kinderkrebs-Patienten ist ein Thema, das uns und unserem Dachverband Kinderkrebs Schweiz […]
Jahresbericht 2018
Im Jahr 2018 konnte die Stiftung erneut über eine halbe Million Franken zugunsten betroffener Kinder und Familien einsetzen. Im Jahresbericht erfahren Sie nicht nur, wie wir die uns anvertrauten Spenden und Förderbeiträge zum Wohle der erkrankten Kinder und Jugendlichen in Projekten einsetzen, sondern auch, wie hoch die dafür notwendigen Administrations- und Fundraisingkosten unserer Stiftung waren.Wir […]
Stadtlauf
Zeige Herz für krebskranke Kinder am Basler Stadtlauf – ein grosser Erfolg Unsere Erfolgsgeschichte «Zeige Herz für krebskranke Kinder am Basler Stadtlauf» hat letzten Samstag ein neues Kapital geschrieben. Insgesamt haben in diesem Jahr über 11‘000 Herzen als Zeichen der Solidarität für krebskranke Kinder und ihre Familien geleuchtet. Motiviert von der grosszügigen Spende der Basler […]
Ich habe den Krebs besiegt!
Elin hat es geschafft. Elin aus Oberbüren (SG) war vier, als sie erkrankte. Heute, zehn Jahre später, ist sie gesund. Daran haben viele Menschen einen grossen Anteil: die Ärzte, ihre Familie, die Freunde. Und auch ihr Glaube gab ihr Kraft. Elin möchte krebskranken Kindern Mut machen. Hier geht es zu ihrer Geschichte.
Anerkennungspreis für Pirmin Schwegler
Mit dem Anerkennungspreis der Krebsliga Schweiz werden Personen oder Organisationen ausgezeichnet, die sich für die Verbesserung der Situation von Patientinnen und Patienten einsetzen. Insbesondere werden innovative Projekte oder Erfindungen preisgekrönt, die Krebskranken eine Hilfe sind. Der Preis ist mit 5’000 Franken dotiert. Bei der Verleihung im letzten Jahr war unser Stiftungsratsmitglied Prof. (em.) Dr. med. […]
Stammzellspender werden – was heisst das eigentlich?
Etwa 35.000 Menschen jährlich bekommen in Deutschland die Schock-Diagnose Leukämie – so auch Alexander. Oft stehen die Heilungschancen gut – wenn ein passender Spender rechtzeitig gefunden wird. Alexander hatte Glück und will nun weitere Lebensretter rekrutieren. Dazu engagiert er sich bei „AIAS“, einem Verein, der mehr Studenten für die Knochenmarkspenderdatei registrieren will. Und hier ist […]
Benefizveranstaltung 21. April 2018 – Reithalle Wenkenhof, Riehen
Was für ein grossartiger Abend. Wir sind immer noch überwältigt von einem musikalischen und kulinarischen Feuerwerk. Die Opernsängerin Regula Mühlemann und das Kammerorchester Basel unter der Leitung von Umberto Benedetti Michelangeli betörten unsere Ohren. Gleichzeitig wurden die Geschmacks- und Geruchssinne von der Sterne-Köchin Tanja Grandits und ihrem Team verwöhnt. Die Reithalle im Wenkenhof Riehen war […]
Jahresbericht 2017
Eine halbe Million Franken zugunsten krebskranker Kinder Im vergangenen Jahr haben wir knapp 600’000 Franken für die kranken Kinder und ihre Familien eingesetzt. Wir arbeiten dabei eng mit dem Universitäts-Kinderspital beider Basel (UKBB) und anderen Organisationen zusammen. Im Jahresbericht lesen Sie, dass… Familien bei finanziellen Engpässen rasch entlastet wurden. Eltern dank unserer Wohnung in der […]